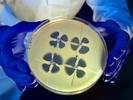

Jon Hamilton appears in the following:
A Database Of All Things Brainy
Thursday, May 14, 2015
Researchers in Seattle are busy cataloging what scientists have learned. For now that includes detailed information on 240 mouse cells. Next up: a data trove of details on human brain cells.
The Shipwreck That Led Confederate Veterans To Risk All For Union Lives
Monday, April 27, 2015
On April 27, 1865, a steamboat named the Sultana exploded and sank while transporting Union soldiers up the Mississippi. An estimated 1,800 people died, but few today have heard of this disaster.
Thoughts Can Fuel Some Deadly Brain Cancers
Thursday, April 23, 2015
A doctor-scientist's long quest to help children with a rare form of brain cancer has led to the discovery that high levels of brain activity can make glioma tumors grow faster.
No Rest For Your Sleeping Brain
Tuesday, April 14, 2015
No wonder the brain needs so much energy. The same coordinated activity that allows you to retrieve a specific memory, like what you had for breakfast, continues at rest and even during sleep.
Sushi Science: A 3-D View Of The Body's Wasabi Receptor
Wednesday, April 08, 2015
The same receptor on nerve endings that makes sinuses tingle when we eat wasabi plays an important role in the pain of inflammation. The first 3-D view of the receptor could lead to better pain drugs.
Hackers Teach Computers To Tell Healthy And Sick Brain Cells Apart
Tuesday, March 31, 2015
Scientists are still better than computers at assessing a neuron's health by looking at its shape. But an effort that includes an international series of hackathons could help speed the process.
No Easy, Reliable Way To Screen For Suicide
Tuesday, March 31, 2015
Clinicians correctly predict a suicide attempt about half the time — no better than a coin toss. Certain tests of involuntary responses, although still experimental, aim to improve the odds.
University And Biotech Firm Team Up On Colorblindness Therapy
Wednesday, March 25, 2015
Six years ago, husband-and-wife scientists used gene therapy to cure colorblindness in monkeys. Now they're trying to make it work for the millions of people with faulty color vision.
Many Doctors Who Diagnose Alzheimer's Fail To Tell The Patient
Tuesday, March 24, 2015
Only about half of Medicare patients are told of the diagnosis by their doctor, a study finds. That compares to 90 percent of patients diagnosed with cancer.
Clues To Autism, Schizophrenia Emerge From Cerebellum Research
Monday, March 16, 2015
The brain's cerebellum helps shape thinking and emotion, as well as physical coordination, research shows. Could stimulating that part of the brain help ease some aspects of autism and schizophrenia?
A Man's Incomplete Brain Reveals Cerebellum's Role In Thought And Emotion
Monday, March 16, 2015
Jonathan Keleher is one of a handful of people known to have lived their entire lives without a cerebellum. His experiences are helping scientists show how this brain structure helps shape who we are.
Mad Cow Research Hints At Ways To Halt Alzheimer's, Parkinson's
Monday, March 09, 2015
Corinne Lasmezas began her career studying a disease that destroys the brains of cattle. Now she's using what she learned to search for drugs that can stop human brain diseases.
Why The 'Nightmare Superbug' Isn't As Scary As It Sounds
Friday, February 20, 2015
The "nightmare superbug" that contributed to two deaths in California isn't as scary as it sounds. But the outbreak does highlight a growing problem with drug-resistant germs.
Why California's Superbug Outbreak Isn't As Scary As It Seems
Thursday, February 19, 2015
News reports are describing a "nightmare superbug" killing people in California. But scientists who study infectious diseases say the risk from this outbreak doesn't live up to the alarming headlines.
"It's not something that is likely to spread around the community or is a cause for alarm," says David ...
Pain Really Is All In Your Head And Emotion Controls Intensity
Wednesday, February 18, 2015
Humiliation, fear and unpredictability all turn up the volume on pain, research shows. And meditation can turn down pain's intensity, according to scientists who are starting to figure out why.
Beyond BPA: Court Battle Reveals A Shift In Debate Over Plastic Safety
Monday, February 16, 2015
In 2007, a plastic called Tritan became a hit, partly because it was free of the chemical BPA. Then a competitor began suggesting that Tritan products contained other chemicals that act like estrogen.
Once A Vaccine Skeptic, This Mom Changed Her Mind
Wednesday, February 04, 2015
Juniper Russo wants what is best for her daughter Vivian, and she sometimes questions mainstream medicine. But after three years of soul searching, she decided what was best was vaccination.
Leaky Blood Vessels In The Brain May Lead To Alzheimer's
Friday, January 23, 2015
As vessels become more porous, researchers say, they allow toxins in the bloodstream to reach, and damage, delicate brain cells and raise the risk for dementia.
From The Mouths Of Apes, Babble Hints At Origins of Human Speech
Wednesday, January 14, 2015
You say banana; this orangutan says ... well, it's hard to tell what she's saying. But the rhythmic, speechlike sounds of the zoo-dwelling ape have started scientists talking.
Brain Scans May Help Predict Future Problems, And Solutions
Wednesday, January 07, 2015
Brain imaging can help researchers tell if people are more likely to be able to quit smoking or have trouble with reading. But those tests aren't yet ready for the doctor's office or classroom.